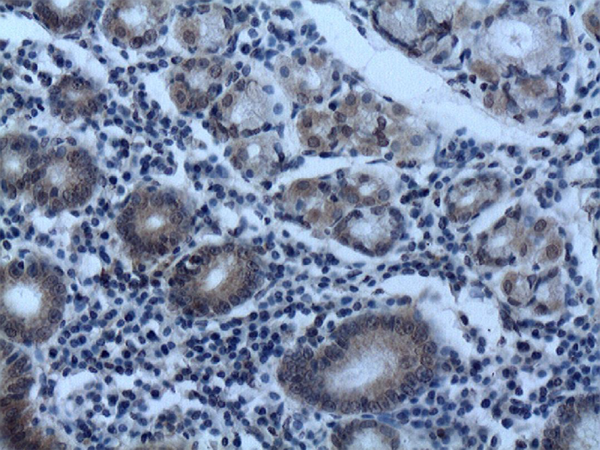
一抗

中文名稱:小鼠抗AFP單克隆抗體

|
Background: |
This gene encodes alpha-fetoprotein, a major plasma protein produced by the yolk sac and the liver during fetal life. Alpha-fetoprotein expression in adults is often associated with hepatoma or teratoma. However, hereditary persistance of alpha-fetoprotein may also be found in individuals with no obvious pathology. The protein is thought to be the fetal counterpart of serum albumin, and the alpha-fetoprotein and albumin genes are present in tandem in the same transcriptional orientation on chromosome 4. Alpha-fetoprotein is found in monomeric as well as dimeric and trimeric forms, and binds copper, nickel, fatty acids and bilirubin. The level of alpha-fetoprotein in amniotic fluid is used to measure renal loss of protein to screen for spina bifida and anencephaly. |
|
Applications: |
ELISA, WB, IHC |
|
Name of antibody: |
AFP |
|
Immunogen: |
Fusion protein of human AFP |
|
Full name: |
alpha fetoprotein |
|
Synonyms: |
AFPD; FETA; HPAFP |
|
SwissProt: |
P02771 |
|
IHC positive control: |
Human gastric |
|
IHC Recommend dilution: |
40-200 |
|
WB Predicted band size: |
69 kDa |
|
WB Positive control: |
HepG2 whole cell lysate |
|
WB Recommended dilution: |
1000-5000 |


 購物車
購物車 幫助
幫助
 021-54845833/15800441009
021-54845833/15800441009